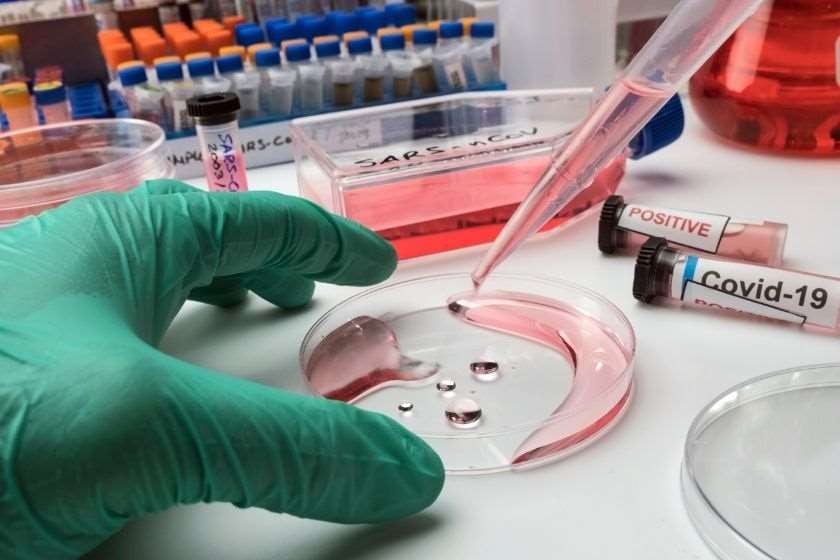

ხანგრძლივი კოვიდი არის მდგომარეობა, რომელიც ხასიათდება გრძელვადიანი შედეგებით, რომლებიც გამოჩნდება ან გრძელდება COVID-19-ის ტიპური გამოჯანმრთელების პერიოდის შემდეგ. ხანგრძლივმა კოვიდმა შეიძლება ნეგატიური გავლენა იქონიოს თითქმის ყველა ორგანოს სისტემაზე, მათ შორის გამოიწვიოს სასუნთქი და ნერვული სისტემის, ნეიროკოგნიტური, ფსიქიკური ჯანმრთელობის, მეტაბოლური, გულ-სისხლძარღვთა და კუჭ-ნაწლავის დარღვევები, აგრეთვე სისუსტე, ზოგადი გადაღლილობა, კუნთოვანი ტკივილები და ანემია. ხშირად აღინიშნება სიმპტომების ფართო სპექტრი, მათ შორის დაღლილობა, თავის ტკივილი, ქოშინი, ანოსმია (ყნოსვის დაკარგვა),კუნთების სისუსტე, დაბალი ცხელება და კოგნიტური დისფუნქცია.
ხანგრძლივი კოვიდის მქონე ადამიანების მიერ ნახსენები სიმპტომები მოიცავს: უკიდურესი დაღლილობა, ხანგრძლივი ხველა, კუნთების სისუსტე, დაბალი ცხელება, კონცენტრაციის უუნარობა (გონების დაბინდვა), მეხსიერების დაქვეითება, განწყობის ცვლილებები, ზოგჯერ თან ახლავს დეპრესია და ფსიქიკური ჯანმრთელობის სხვა პრობლემები, ძილის სირთულეები, თავის ტკივილი, სახსრების ტკივილი, ნემსის ჩხვლეტები ხელებსა და ფეხებში, დიარეა და ღებინება, გემოვნებისა და ყნოსვის დაკარგვა, ყელის ტკივილი და ყლაპვის გაძნელება, დიაბეტი და ჰიპერტენზია, გულძმარვა, გამონაყარი კანზე, ჰაერის უკმარისობა, გულმკერდის ტკივილები, თირკმელების პრობლემები, თირკმელების მწვავე დაზიანება და ქრონიკული თირკმლის დაავადება. ზოგიერთ ადამიანს აწუხებს გრძელვადიანი ნევროლოგიური სიმპტომები, მიუხედავად იმისა, რომ არასოდეს ყოფილა ჰოსპიტალიზებული COVID-19-ის გამო; ბევრ პაციენტს პირველად განუვითარდა დიაბეტი, ასევე გულის, ღვიძლისა და თირკმელების პრობლემები. ხანგრძლივი კოვიდის სიმპტომები შეიძლება გამოწვეული იყოს ოთხი სინდრომით: ფილტვების და გულის მუდმივი დაზიანება, პოსტინტენსიური თერაპიის სინდრომი, პოსტვირუსული დაღლილობა, ზოგჯერ განიხილება როგორც მიალგიური ენცეფალომიელიტი/ქრონიკული დაღლილობის სინდრომი, COVID-19-ის სიმპტომების გახანგრძლივება.

ქსენონის მაგნიტურ-რეზონანსული ტომოგრაფია გამოიყენება ხანგრძლივი კოვიდის შესასწავლად, რადგან ის პაციენტებსა და ექიმებს აძლევს ინფორმაციას ადრე აუხსნელ დაკვირვებებზე. ქსენონის მაგნიტურ-რეზონანსულ ტომოგრაფიას შეუძლია გაზომოს გაზის გაცვლა და მიაწოდოს ინფორმაცია იმის შესახებ, თუ რამდენი ჰაერი შეიწოვება პაციენტის სისხლძარღვში, რაც გამოკვლეულია გრძელვადიანი კოვიდის პაციენტებში. ქსენონის მაგნიტურ-რეზონანსულ ტომოგრაფიას შეუძლია ფილტვების ფუნქციის სამი კომპონენტის რაოდენობრივი განსაზღვრა: ვენტილაცია, ბარიერული ქსოვილის შეწოვა და გაზის გაცვლა. ვენტილაცია ზომავს, თუ როგორ ნაწილდება ჰაერი ფილტვებში და შეუძლია აღმოაჩინოს პოტენციურად დაზიანებული ფილტვის უბნების მდებარეობა, თუ ქსენონი არ აღწევს ამ ადგილებში. ბარიერული ქსოვილის შეწოვა და გაზის გაცვლა ზომავს ჰაერის დიფუზირებას ალვეოლურ-კაპილარულ მემბრანაზე. ამგვარი მეთოდი გვეხმარება იმის დადგენაში, თუ რამდენად კარგად შეიწოვება ჰაერი ფილტვებში, ფილტვის ქსოვილში და მიიღება სისხლით.